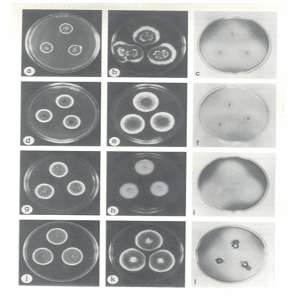

Hình dạng, kích thước, cấu tạo của nấm mốc
Hình dạng và kích thước
Một số ít nâm ở thể đơn bào có hình trứng (yeast=nấm men), đa số có hình sợi (filamentous fungi=nấm sợi), sợi có ngăn vách (đa bào) hay không có ngăn vách (đơn bào). Sợi nấm thường là một ống hình trụ dài có kích thước lớn nhỏ khác nhau tùy loài. Đường kính của sợi nấm thường từ 3-5µm, có khi đến 10µm, thậm chí đến 1mm. Chiều dài của sợi nấm có thể tới vài chục centimet. Các sợi nấm phát triển chiều dài theo kiểu tăng trưởng ở ngọn (Hình 1.1). Các sợi nấm có thể phân nhánh và các nhánh có thể lại phân nhánh liên tiếp tạo thành hệ sợi nấm (mycelium) khí sinh xù xì như bông. Trên môi trường đặc và trên một số cơ chất trong tự nhiên, bào tử nấm, tế bào nấm hoặc một đoạn sợi nấm có thể phát triển thành một hệ sợi nấm có hình dạng nhất định gọi là khuẩn lạc nấm (Hình 1.2)

Cấu tạo
Tế bào nấm có cấu trúc tương tự như những tế bào vi sinh vật chân hạch khác được mô tả và trình bày như ở Hình 1.3

Vách tế bào nấm cấu tạo bởi vi sợi chitin và có hoặc không có celluloz. Chitin là thành phần chính của vách tế bào ở hầu hết các loài nấm trừ nhóm Oomycetina. Những vi sợi chitin được hình thành nhờ vào enzim chitin syntaz (Hình 1.4).

Tế bào chất của tế bào nấm chứa mạng nội mạc (endoplasmic reticulum), không bào (vacuoles), ty thể (mitochondria) và hạt dự trữ (glycogen và lipid), đặc biệt cấu trúc ty thể ở tế bào nấm tương tự như cấu trúc ty thể ở tế bào thực vật. Ngoài ra, tế bào nấm còn có ribô thể (ribosomes) và những thể khác chưa rỏ chức năng.
Tế bào nấm không có diệp lục tố, một vài loài nấm có rải rác trong tế bào một loại sắc tố đặc trưng mà Matsueda và ctv. (1978) đầu tiên ly trích được và gọi là neocercosporin (C29H26O10) có màu tím đỏ ở nấm Cercosporina kikuchi.
Tế bào nấm không nhất thiết có một nhân mà thường có nhiều nhân. Nhân của tế bào nấm có hình cầu hay bầu dục với màng đôi phospholipid và protein dầy 0,02 μm, bên trong màng nhân chứa ARN và ADN.
Dinh dưỡng và tăng trưởng của nấm mốc
Hầu hết các loài nấm mốc không cần ánh sáng trong quá trình sinh trưởng. Tuy nhiên, có một số loài lại cần ánh sáng trong quá trình tạo bào tử (Buller, 1950). Nhiệt độ tối thiểu cần cho sự phát triển là từ 2oC đến 5oC, tối hảo từ 22oC đến 27oC và nhiệt độ tối đa mà chúng có thể chịu đựng được là 35oC đến 40oC, cá biệt có một số ít loài có thể sống sót ở OoC và ở 60oC. Nói chung, nấm mốc có thể phát triển tốt ở môi trường acit (pH=6) nhưng pH tối hảo là 5 - 6,5, một số loài phát triển tốt ở pH < 3 và một số ít phát triển ở pH > 9 (Ingold, 1967).
Oxi cũng cần cho sự phát triển của nấm mốc vì chúng là nhóm hiếu khí bắt buộc và sự phát triển sẽ ngưng khi không có oxi và dỉ nhiên nước là yếu tố cần thiết cho sự phát triển.
Theo Alexopoulos và Minns (1979) cho biết nấm mốc có thể phát triển liên tục trong 400 năm hay hơn nếu các điều kiện môi trường đều thích hợp cho sự phát triển của chúng.
Nấm mốc không có diệp lục tố nên chúng cần được cung cấp dinh dưỡng từ bên ngoài (nhóm dị dưỡng), một số sống sót và phát triển nhờ khả năng ký sinh (sống ký sinh trong cơ thể động vật hay thực vật) hay hoại sinh (saprophytes) trên xác bã hữu cơ, cũng có nhóm nấm rễ hay địa y sống cộng sinh với nhóm thực vật nhất định.
Theo Alexopoulos và Mims (1979) cho biết nguồn dưỡng chất cần thiết cho nấm được xếp theo thứ tự sau: C, O, H, N P, K, Mg, S, B, Mn, Cu, Zn, Fe, Mo và Ca. Các nguyên tố này hiện diện trong các nguồn thức ăn vô cơ đơn giản như glucoz, muối ammonium... sẽ được nấm hấp thu dễ dàng, nếu từ nguồn thức ăn hữu cơ phức tạp nấm sẽ sản sinh và tiết ra bên ngoài các loại enzim thích hợp để cắt các đại phân tử này thành những phân tử nhỏ để dể hấp thu vào trong tế bào.
Sinh sản của nấm mốc
Nói chung, nấm mốc sinh sản dưới 2 hình thức: vô tính và hữu tính. Trong sinh sản vô tính, nấm hình thành bào tử mà không qua việc giảm phân, trái lại trong sinh sản hữu tính nấm hình thành 2 loại giao tử đực và cái.
Sinh sản vô tính
The Alexopoulos và Mims (1979), nấm mốc sinh sản vô tính thể hiện qua 2 dạng: sinh sản dinh dưỡng bằng đoạn sợi nấm phát triển dài ra hoặc phân nhánh và sinh sản bằng các loại bào tử.
Một số loài nấm có những bào tử đặc trưng như sau:
a. Bào tử túi (bào tử bọc)(sporangiospores): các bào tử động (zoospores) (Hình 1.5 a, b, c) có ở nấmSaprolegnia và bào tử túi (sporangiopores) ở nấm Mucor, Rhizopus (Hình 1.6) chứa trong túi bào tử động (zoosporangium) và túi bào tử (sporangium) được mang bỡi cuống túi bào tử(sporangiophores).


b. Bào tử đính (conidium): các bào tử đính không có túi bao bọc ở giống nấm Aspergillus, Penicillium, ... Hình dạng, kích thước, màu sắc, trang trí và cách sắp xếp của bào tử đính thay đổi từ giống này sang giống khác và được dùng làm tiêu chuẩn để phân loại nấm.
Cuống bào tử đính dạng bình có thể không phân nhánh như ở Aspergillus (Hình 1.7) hay dạng thẻ phân nhánh như ở Penicillium (Hình 1.8). Bào tử đính hình thành từ những cụm (cluster) trên những cuống bào tử đính ở Trichoderma (Hình 1.9).



Ở giống Microsporum và Fusarium, có hai loại bào tử đính: loại nhỏ, đồng nhất gọi là tiểu bào tử đính (microconidia) (Hình 1.10 a) , loại lớn, đa dạng gọi là đại bào tử đính (macroconidia) (Hình 1.11 b)


c. Bào tử tản (Thallospores): trong nhiều loài nấm men và nấm mốc có hình thức sinh sản đặc biệt gọi là bào tử tản. Bào tử tản có thể có những loại sau:
- Chồi hình thành từ tế bào nấm men: Cryptococcus và Candida là những loại bào tử tản đơn giản nhất, gọi là bào tử chồi (blastospores)
- Giống Ustilago có những sợi nấm có xuất hiện tế bào có vách dầy gọi là bào tử vách dầy còn gọi là bào tử áo (chlamydospores) (Hình 1. 11 c). Vị trí của bào tử vách dầy ở sợi nấm có thể khác nhau tùy loài.
3. Giống Geotrichum và Oospora có sợi nấm kéo thẳng, vuông hay chử nhật và tế bào vách dầy gọi là bào tử đốt (arthrospores) (Hình 1.12)

Sinh sản hữu tính
Sinh sản hữu tính xảy ra khi có sự kết hợp giữa hai giao tử đực và cái (gametes) có trải qua giai đoạn giảm phân. Quá trình sinh sản hữu tính trải qua 3 giai đoạn:
- Tiếp hợp tế bào chất (plasmogamy) với sự hòa hợp 2 tế bào trần (protoplast) của 2 giao tử
- Tiếp hợp nhân (karyogamy) với sự hòa hợp 2 nhân của 2 tế bào giao tử để tạo một nhân nhị bội (diploid)
- Giảm phân (meiosis) giai đoạn này hình thành 4 bào tử đơn bội (haploid) qua sự giảm phân từ 2n NST (nhị bội) thành n NST (đơn bội).
Theo Machlis (1966) tất cả các giai đoạn trên kể cả giai đoạn tạo cơ quan sinh dục được điều khiển bởi một số kích thích tố sinh dục (sexual hormones).
Cơ quan sinh dục của nấm mốc có tên là túi giao tử (gametangia) có 2 loại: cơ quan sinh dục đực gọi là túi đực (antheridium) chứa các giao tử đực (antherozoids), còn cơ quan sinh dục cái gọi túi noãn(oogonium) chứa giao tử cái hay noãn, khi có sự kết hợpgiữagiao tử đực và noãnsẽ tạo thành bào tử, bào tử di động được gọi là bào tửđộng (zoospores).
Kiểu hai sợi nấm có giới tính đực và cái tiếp hợp nhau sinh ra bào tử có tên là tiếp hợp tử (myxospores), tiếp hợp tử là đặc trưng của nhóm nấm Myxomycetes (Hình 1.13).
Bào tử sinh dục khi hình thành có dạng túi gọi là nang (ascus) và túi này chứa những bào tử gọi là bào tử nang (ascospores). Nang và bào tử nang là đặc trưng của nhóm Ascomycetes (Hình 1.14) .
Trong nhóm Basidiomycetes, 4 bào tử phát triển ở phần tận cùng của cấu trúc thể quả gọi là đãm (basidium) và bào tử được gọi là bào tử đãm (basidiospores) (Hình 1.15)
Nhóm Nấm bất toàn (Deuteromycetes=Deuteromycotina)) gồm những nấm cho đến nay chưa biết rõ kiểu sinh sản hữu tính của chúng.


Hình 1.13. Bào tử nang ở Saccharomyces cerevisiae(theo Samson và ctv. 1995)

Vị trí và vai trò của nấm mốc
Nấm mốc có ảnh hưởng xấu đến cuộc sống con người một cách trực tiếp bằng cách làm hư hỏng, giảm phẩm chất lương thực, thực phẩm trước và sau thu hoạch, trongchế biến, bảo quản. Nấm mốc còn gây hư hại vật dụng, quần áo... hay gây bệnh cho người, động vật khác và cây trồng. Tuy nhiên, các qui trình chế biến thực phẩm có liên quan đến lên men đều cần đến sự có mặt của vi sinh vật trong đó có nấm mốc. Nấm mốc cũng giúp tổng hợp những loại kháng sinh (penicillin, griseofulvin), acit hữu cơ (acit oxalic, citric, gluconic...), vitamin (nhóm B, riboflavin), kích thích tố (gibberellin, auxin, cytokinin), một số enzim và các hoạt chất khác dùng trong công nghiệp thực phẩm và y, dược ... đã được sử dụng rộng rãi trên thế giới. Ngoài ra, nấm còn giử vai trò quan trọng trong việc phân giải chất hữu cơ trả lại độ mầu mỡ cho đất trồng.
Một số loài thuộc giống Rhizopus, Mucor, Candida gây bệnh trên người, Microsporum gây bệnh trên chó, Aspergillus fumigatus gây bệnh trên chim; Saprolegnia và Achlya gây bệnh nấm ký sinh trên cá. Những loài nấm gây bệnh trên cây trồng như Phytophthora, Fusarium, Cercospora.... đặc biệt nấm Aspergilus flavus và Aspergillus fumigatusphát triển trên ngũ cốc trong điều kiện thuận lợi sinh ra độc tố aflatoxin.
Bên cạnh tác động gây hại, một số loài nấm mốc rất hữu ích trong sản xuất và đời sống như nấm ăn, nấm dược phẩm (nấm linh chi, Penicillium notatum tổng hợp nên penicillin, Penicillium griseofulvum tổng hợp nên griseofulvin...), nấm Aspergillus niger tổng hợp các acit hữu cơ như acit citric, acit gluconic, nấm Gibberellafujikuroi tổng hợp kích thích tố gibberellin và một số loài nấm thuộc nhóm Phycomycetina hay Deuteromycetina có thể ký sinh trên côn trùng gây hại qua đó có thể dùng làm thiên địch diệt côn trùng. Ngoài ra, những loài nấm sống cộng sinh với thực vật như Nấm rễ (Mycorrhizae), giúp cho rễ cây hút được nhiều hơn lượng phân vô cơ khó tan và cung cấp cho nhu cầu phát triển của cây trồng.
Nấm còn là đối tượng nghiên cứu về di truyền học như nấm Neurospora crassa, nấm Physarum polycephalum dùng để tổng hợp ADN và những nghiên cứu khác.
Phân loại nấm mốc
Đầu tiên, nấm được sắp xếp theo tiến hóa như mô hình dưới đây: (Hình 1.15)
Dayal (1975) liệt kê 7 đặc tính để phân loại nấm mốc như sau:
- đặc điểm hình thái
- ký chủ đặc thù
- đặc điểm sinh lý
- đặc điểm tế bào học và di truyền học
- đặc điểm kháng huyết thanh
- đặc tính sinh hóa chung
- phân loại số học

Theo Gwynne-Vaughan và Barnes (1937) chia nấm thành 3 lớp chính: Phycomycetes, Ascomycetes và Basidiomycetes dựa trên khuẩn ty có vách ngăn ngang hay không và đặc điểm của bào tử. Theo Stevenson (1970) đã phân loại nấm trong ngành Mycota gồm 6 lớp: Chytridiomycetes, Oomycetes, Zygomycetes, Ascomycetes, Basidiomycetes, và Deuteromycetes. Gần đây, Kurashi (1985) nhấn mạnh đến tầm quan trọng của hệ thống ubiquinon trong phân loại nấm mốc cũng như ứng dụng kỹ thuật sinh học phân tử để khảo sát đa dạng di truyền và qua mối liên hệ di truyền phân loại lại cho chính xác hơn.